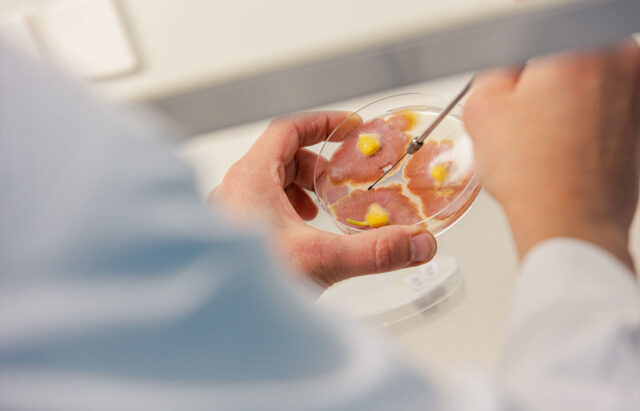

Phytopathologie
„Wir halten einen Zoo an Schadinsekten“
Die Phytopathologie ist ein wachsendes und sehr dynamisches Forschungsgebiet. Kerstin Krüger hat im März 2021 die Leitung des Teams bei KWS übernommen. Im Interview berichtet sie, warum das Wissen um Blattläuse, Viren und Co. so wichtig ist und welche Rolle die Phytopathologie bei der Entwicklung von Pflanzensorten spielt.
Das Verbot einiger chemischer Pflanzenschutzmittel, der Klimawandel und die Globalisierung bringen viele „alte“ Pflanzenkrankheiten und -schädlinge zurück oder erfordern neue Ansätze, um Erträge auf nachhaltigere Weise zu sichern. Kerstin Krüger stellt sich diesen Herausforderungen mit einer aktiven Haltung und einem tatkräftigen Team von Wissenschaftlerinnen und Wissenschaftlern, Assistentinnen und Assistenten, die sich mit wichtigen Krankheiten und Schädlingen aller KWS Kulturpflanzen auseinandersetzen.
Wie sind Sie zur Phytopathologie gekommen?
Die Phytopathologie verbindet meine beiden Interessen: Pflanzenwissenschaften und Insekten. Insekten faszinieren mich wegen ihrer erstaunlichen Vielfalt. Sie sind von grundlegender Bedeutung für unsere Ökosysteme, aber einige Arten bedrohen Nutzpflanzen, indem sie diese entweder direkt fressen oder Krankheitserreger übertragen.
Ich habe die letzten dreißig Jahre in Südafrika verbracht, wo ich als außerordentliche Professorin an der Universität von Pretoria immer noch junge Wissenschaftler ausbilde. Ich habe im Bereich der angewandten Insektenkunde und in der Landwirtschaft geforscht. Meine Arbeiten konzentrieren sich auf die nicht chemische Bekämpfung von Insekten als Vektoren von Pflanzenkrankheiten.
Was war der Hauptgrund dafür, dass Sie von der Forschung an einer Universität zu KWS gewechselt sind?
Meine Leidenschaft gilt der Wissenschaft und dem Schließen der Lücke zwischen der akademischen Welt und der Landwirtschaft. In der Vergangenheit habe ich bei Projekten in Zusammenhang mit Pflanzenkrankheiten sehr eng mit Landwirten zusammengearbeitet. Bei KWS fasziniert mich die Möglichkeit, einen direkteren Einfluss zu haben, indem ich die Forschung aufs Feld bringe. Ich kann mit unserem Team die Phytopathologie weiterentwickeln und dabei unterstützen, die aktuellen Herausforderungen in der Nachhaltigkeit und durch den Klimawandel zu bewältigen, indem wir moderne technologische Fortschritte nutzen und innovative Lösungen anbieten.

Kerstin Krüger ist seit März 2021 Leiterin unserer Phytopathologie. Sie kehrt von der Universität Pretoria in Südafrika nach Deutschland zurück und freut sich darauf, eine Brücke zwischen Wissenschaft und den Herausforderungen der landwirtschaftlichen Praxis zu schlagen.
Warum braucht ein Pflanzenzüchtungsunternehmen eine Abteilung für Phytopathologie?
Malaria ist ein bekanntes Beispiel für eine durch Insekten übertragene menschliche Krankheit. Auch bei Pflanzen gibt es viele durch Insekten übertragene Krankheiten. So wird zum Beispiel die Vergilbungskrankheit der Zuckerrübe durch verschiedene Pflanzenviren verursacht, die von Blattläusen übertragen werden, die sich vom Pflanzensaft ernähren. Krankheiten können auch durch andere Organismen übertragen werden: Das Rübenwurzelbärtigkeitsvirus, das die Rhizomania bei Zuckerrüben verursacht, wird durch Pilze übertragen, die im Boden leben.
Zu den wichtigsten Fachgebieten unserer Gruppe gehören Mykologie (Pilzkunde), Nematologie (Fadenwurmkunde), Entomologie (Insektenkunde) und Pflanzenschutz. Wir arbeiten mit fast allen Abteilungen der KWS zusammen, um Kolleginnen und Kollegen aus Züchtung und Produktentwicklung zu unterstützen und strategische Entscheidungen zum Portfolio zu treffen. Unsere Aufgaben umfassen Routinedienstleistungen wie Krankheitsdiagnostik, Prüfung von neuem Zuchtmaterial, Krankheits- und Schädlingsmonitoring sowie Pflanzenschutz im Gewächshaus und im Freiland. Weitere Kernaktivitäten sind das Entwickeln und Etablieren neuer Tests und Methoden. Außerdem beraten wir unsere Kolleginnen und Kollegen weltweit in phytopathologischen Fragen.
Unsere Aufgaben sind in den letzten Jahren erheblich gewachsen. Gründe sind der zunehmende Krankheits- und Schädlingsdruck sowie die Nachhaltigkeitsziele der EU, den Einsatz und das Risiko von chemischem Pflanzenschutz bis 2030 zu halbieren. Wir sind bereits zehn Assistentinnen und Assistenten und vier Wissenschaftlerinnen und Wissenschaftler und expandieren weiter, um den aktuellen und zukünftigen Anforderungen gerecht zu werden.
Wie sieht der normale Ablauf bei der Erkennung und Diagnose von Problemen mit Schädlingen oder Krankheiten aus?
Unsere Arbeit beginnt in der Regel mit ersten Beobachtungen auf dem Feld, die oft von Landwirten stammen. Auf diese Weise lassen sich beispielsweise Pilzkrankheiten feststellen, die zuvor mit chemischen Mitteln unterdrückt wurden, oder erste Pflanzen, die nicht mehr resistent gegen Schädlinge oder Krankheiten sind. Die Nähe der KWS zum Anbauer ermöglicht es uns, frühzeitig zu reagieren.
Wir kultivieren die verschiedenen Krankheitserreger und halten einen regelrechten „Zoo“ an Insektenvektoren und Schadinsekten – wir züchten tatsächlich die Feinde fast aller KWS Kulturen! Diese werden eingesetzt, um Pflanzen zu infizieren oder zu befallen, die entweder im Gewächshaus oder auf dem Feld angebaut und je nach ihrer Anfälligkeit bewertet werden.
Unsere Arbeit ist noch sehr praxisorientiert. Es gibt jedoch Pläne, das Auswerten der Pflanzen zu digitalisieren, was sehr spannend ist.
An welchen Standorten wird an Pflanzenkrankheiten geforscht?
Unsere zentrale Abteilung befindet sich in Einbeck, und wir machen hier einen Großteil unserer experimentellen Arbeiten. Es ist jedoch immer am besten, wenn man sich mit regional auftretenden Krankheiten und Schädlingen in ihrer ursprünglichen Umgebung beschäftigt. Wenn es sich beispielsweise um einen Schädling in Chile handelt, können wir die südamerikanische Station unterstützen, indem wir unser Know-how für die Anlage von Kulturen, das Erstellen von Protokollen und die Unterstützung bei der Prüfung und Analyse der Ergebnisse weitergeben. Bei globaleren Problemen können die Tests parallel an verschiedenen Standorten gemacht werden.
Gibt es Kooperationen mit anderen Unternehmen oder Universitäten?
Es bestehen verschiedene Kooperationen in mehreren Regionen der Welt. Bei neuen Krankheiten oder unbekannten Überträgerinsekten arbeiten wir in der Grundlagenforschung mit Forschungseinrichtungen zusammen.
KWS engagiert sich für eine nachhaltige Landwirtschaft. Welchen Beitrag leistet die Phytopathologie?
Durch das Verbot einiger chemischer Pflanzenschutzmittel wie beispielsweise der Neonicotinoide werden viele Krankheiten und Schädlinge wieder zu einem Problem. Chemische Mittel müssen durch resistente Sorten und, wenn möglich, durch biologische Bekämpfung ersetzt werden. Darüber hinaus bringt der Klimawandel neue Belastungen für die Pflanzen mit sich. Wir beobachten beispielsweise zunehmende Populationsgrößen oder eine Ausweitung des Verbreitungsgebiets einiger Schädlinge. Außerdem bedeutet die Globalisierung, dass Pflanzenkrankheiten und Schädlinge in neue Regionen transportiert werden.
Wir müssen auf diese neuen Herausforderungen vorbereitet sein, und unser Ansatz ist es, proaktiv zu handeln. Unser Ziel ist es, eine wesentliche Rolle bei der Entwicklung von Produkten zu spielen, die es den Landwirten ermöglichen, nachhaltig und rentabel zu arbeiten. |
© KWS SAAT SE & Co. KGaA 2026